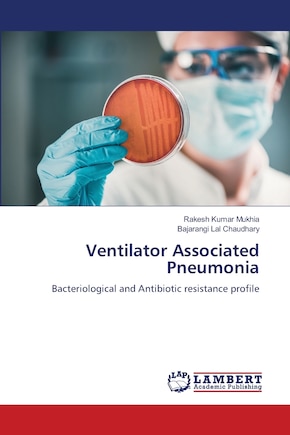
Couverture

Ramasser gratuitement à
Trouver en magasinFaire livrer
0 articles
Aucun article trouvé
Try adjusting your filters to see more items.
Livre numérique Kobo
97,99 $
2 formats offerts
Couverture souple
205,00 $